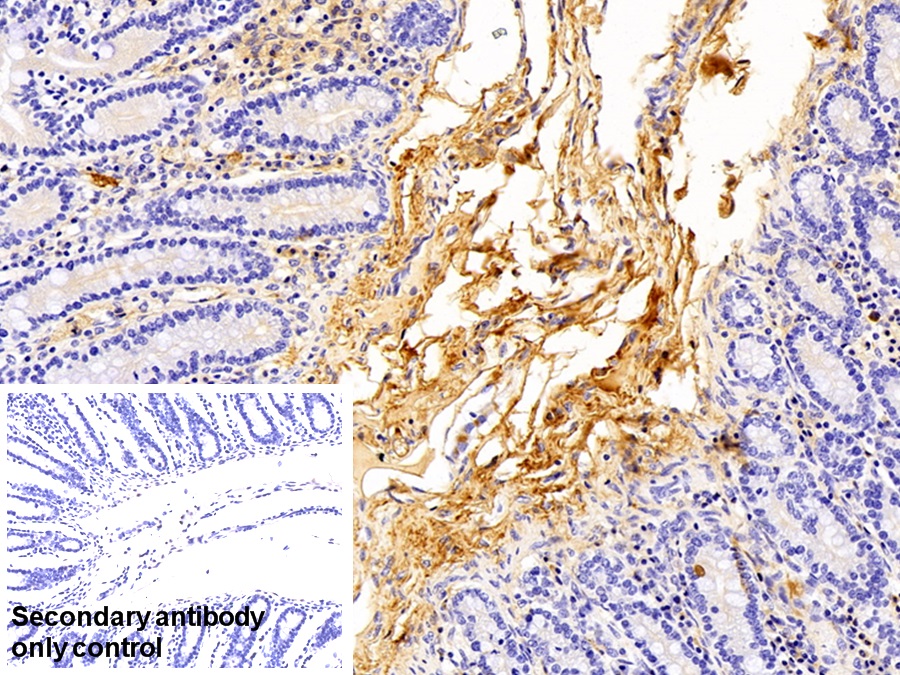

Polyclonal Antibody to Immunoglobulin G (IgG)
- Product No.PAA544Hu01
- Organism SpeciesHomo sapiens (Human) Same name, Different species.
- SourcePolyclonal antibody preparation
- HostRabbit
- Potencyn/a
- Ig Type IgG
- PurificationAntigen-specific affinity chromatography followed by Protein A affinity chromatography
- LabelNone
- Immunogen NPA544Hu01-Native Immunoglobulin G (IgG)
- Buffer Formulation0.01M PBS, pH7.4, containing 0.05% Proclin-300, 50% glycerol.
- TraitsLiquid
- Concentration0.5mg/mL
- Organism Species MoreSus scrofa; Porcine (Pig)
- ApplicationsWB; IHC
If the antibody is used in flow cytometry, please check FCM antibodies. - DownloadInstruction Manual
- UOM 20µl100µl 200µl 1ml 10ml
- FOB
US$ 90
US$ 210
US$ 300
US$ 750
US$ 3000
For more details, please contact local distributors!
SPECIFITY
The antibody is a rabbit polyclonal antibody raised against IgG. It has been selected for its ability to recognize IgG in immunohistochemical staining and western blotting.
USAGE
Western blotting: 0.01-2µg/mL;
Immunohistochemistry: 5-20µg/mL;
Immunocytochemistry: 5-20µg/mL;
Optimal working dilutions must be determined by end user.
STORAGE
Store at 4°C for frequent use. Stored at -20°C in a manual defrost freezer for two year without detectable loss of activity. Avoid repeated freeze-thaw cycles.
STABILITY
The thermal stability is described by the loss rate. The loss rate was determined by accelerated thermal degradation test, that is, incubate the protein at 37°C for 48h, and no obvious degradation and precipitation were observed. The loss rate is less than 5% within the expiration date under appropriate storage condition.
GIVEAWAYS
INCREMENT SERVICES
| Magazine | Citations |
| Journal of Animal and Veterinary Advances | Tryptophan Stimulates Immune Response in Broiler Chickens Challenged with Infectious Bursal Disease Vaccine Medwell: 2010610616 |
| Journal of Animal and Veterinary Advances | Immunostimulatory Effects of Arginine in Broiler Chickens Challenged with Vaccine Strain of Infectious Bursal Disease Virus Medwell: 2010594600 |
| international Journal of food and nutritional sciences | EVALUATION OF PHYSICO-CHEMICAL PROPERTIES OF COLOSTRUM SUPPLEMENTED DAHI Ijfans: Source |
| Poultry Science | Effects of Clostridium butyricum on growth performance, immune function, and cecal microflora in broiler chickens challenged with Escherichia coli K88 Pubmed: 24570422 |
| Pharmaceutical Development and Technology | Foot and Mouth Disease virus-loaded fungal chitosan nanoparticles for intranasal administration: impact of formulation on physicochemical and immunological characteristics Pubmed: 23590209 |
| BioMed Research International | The Effect of CXC Motif Chemokine 13 on Hepatocellular Carcinoma Associates with Wnt Signaling Hindawi:Source |
| Journal of Proteomics | Proteomics on porcine haptoglobin and IgG/IgA show protein species distribution and glycosylation pattern to remain similar in PCV2-SD infection Pubmed:24576640 |
| Int J Occup Environ Health. | Liver functions in silica-exposed workers in Egypt: possible role of matrix remodeling and immunological factors Pubmed:24999850 |
| Food & Function | Dietary squid ink polysaccharide could enhance SIgA secretion in chemotherapeutic mice Pubmed:25308407 |
| Oncology Reports | Beneficial effect of T follicular helper cells on antibody class switching of B cells in prostate cancer Pubmed:25529861 |
| Biomed Res Int | The Effect of C-X-C Motif Chemokine 13 on Hepatocellular Carcinoma Associates with Wnt Signaling PubMed: 26161394 |
| Protein Pept Lett | Stabilization of Human Immunoglobulin G Encapsulated within Biodegradable Poly (Cyclohexane-1, 4-diyl Acetone Dimethylene Ketal) (PCADK)/ Poly (Lactic-co-Glycolic Acid) (PLGA) Blend Microspheres PubMed: 26268563 |
| Electrophoresis | Growth promotion in pigs by oxytetracycline coincides with down reCavia (Guinea pig )lation of serum inflammatory parameters and of hibernation‐associated protein HP‐27 Pubmed:26914286 |
| Neuropeptides | Neuropeptide Y stimulates osteoblastic differentiation and VEGF expression of bone marrow mesenchymal stem cells related to canonical Wnt signaling activating in vitro. Pubmed:26707636 |
| Archives of Biological Sciences | Effect of oral administration of Lactobacillus paracasei L9 on mouse systemic immunity and the immune response in the intestine pid:46641600021Z |
| Asian J Pharm Clin Res | INFLUENCE OF ZINCOVIT DROP (NUTRITIONAL FOOD SUPPLEMENT) ON IMMUNE SYSTEM IN NORMAL AND CYCLOPHOSPHAMIDE INTOXICATED WISTAR RATS journals:3790 |
| journal of biotechnology | Expression of α-1,6-fucosyltransferase (FUT8) in rice grain and immunogenicity evaluation of plant-specific glycans. pubmed:28013072 |
| Sci Rep. | Long-term use of ceftriaxone sodium induced changes in gut microbiota and immune system. pubmed:28220870 |
| Toxicology Research | Effect of dietary protein or calcium supplement on the expression of collagen I and dentine phosphoprotein of rats with dental fluorosis C6TX00288A |
| ntervirology | Exposure of Piglets to Enteroviruses Investigated by an Immunoassay Based on the EV-G1 VP4 Peptide pubmed:27694750 |
| Biomedicine & Pharmacotherapy | Icariin promotes osteogenic differentiation of rat bone marrow stromal cells by activating the ERα-Wnt/β-catenin signaling pathway. pubmed:27764755 |
| Food and Agricultural Immunology | Effects of fermented cottonseed meal on growth performance, serum biochemical parameters, immune functions, antioxidative abilities, and cecal microflora in broilers 10.108:09540105.2017.1311308 |
| Biomedicine & Pharmacotherapy | In vitro and in vivo immunomodulatory potential of Pedicularis longiflora and Allium carolinianum in alloxan-induced diabetes in rats pubmed:29091887 |
| Journal of Biochemical and Molecular Toxicology | Fluoride or/and aluminum induced toxicity in guinea pig teeth with the low expression of dentine phosphoprotein 10.1002/jbt.21912 |
| International Journal of Science and Research | Impact of Silver Nanoparticles on Immune Responses as Vaccine against Activated Staphylococcus aureus Bacteria ISSN: 2319-7064 |
| Molecular Medicine Reports | Protective effects of astragaloside IV against ovalbumin-induced allergic rhinitis are mediated by T-box protein expressed in T cells/GATA-3 and forkhead box protein 3/retinoic acid-related orphan nuclear receptor γt. pubmed:28586019 |
| Revista Brasileira de Zootecnia | Influence of eggshell colour on egg yolk antibody level, incubation results, and growth in broiler breeders 10.1590/s1806-92902017000200004 |
| Water Research | Sub-chronic inhalation of reclaimed water-induced fibrotic lesion in a mouse model Pubmed:29655095 |
| Clinical Immunology | Toll-like receptor 9 ligands increase type I interferon induced B-cell activating factor expression in chronic rhinosinusitis with nasal polyposis Pubmed:30056130 |
| Food and Agricultural Immunology | Effects of and on growth performance, immune function and volatile fatty acid level of caecal digesta in broilers 10.1080:09540105.2018.1457013 |
| Journal of Molecular Neuroscience | A Novel scFv Anti-Aβ Antibody Reduces Pathological Impairments in APP/PS1 Transgenic Mice via Modulation of Inflammatory Cytokines and Aβ-related Enzymes Pubmed:30062438 |
| Biological Trace Element Research | Supplementation of Cr Methionine During Dry Period of Dairy Cows and Its Effect on Some Production and Biochemical Parameters During Early Lactation and on … Pubmed:29497999 |
| Probiotics Antimicrob Proteins | Effect of Multi-Microbial Probiotic Formulation Bokashi on Pro-and Anti-Inflammatory Cytokines Profile in the Serum, Colostrum and Milk of Sows, and in a … Pubmed:29305686 |
| SAGE Open Medicine | Altered immunoglobulins (A and G) in Ghanaian patients with type 2 diabetes Pubmed:29623201 |
| Journal of Biological Chemistry | Biochemical characterization of the PHARC associated serine hydrolase ABHD12 reveals its preference for very long chain lipids Pubmed: 30237167 |
| ACS Applied Materials & Interfaces | Fabrication and characterization of core-shell nanofibers using a next-generation airbrush for biomedical applications Pubmed: 30433758 |
| Molecular Human Reproduction | Phenotypic variations in transferred progeny due to genotype of surrogate mother: Surrogate mother modulates transferred progeny Pubmed: 30445548 |
| Bioscience, Biotechnology, and Biochemistry | In vitro and in vivo cancer cell apoptosis triggered by competitive binding of Cinchona alkaloids to the RING domain of TRAF6 |
| Journal of proteome research | Serum exosomes from newborn piglets restrict porcine epidemic diarrhea virus infection |
| International Immunopharmacology | Ginsenoside Rg3 improves cyclophosphamide-induced immunocompetence in Balb/c mice Pubmed: 30974284 |
| Utjecaj dodatka selena u prihrani na hematološku sliku i biokemijske pokazatelje u jelena lopatara (Dama dama L.) | |
| Biogerontology | Age-related chemokine alterations affect IgA secretion and gut immunity in female mice Pubmed: 32277312 |
| International Journal of Biological Macromolecules | Effects of polysaccharides from Yingshan Yunwu tea on meat quality, immune status and intestinal microflora in chickens Pubmed: 32224178 |
| Pharmaceutics | Efficacy of Local Minocycline Agents in Treating Peri-Implantitis: An Experimental In Vivo Study in Beagle Dogs Pubmed: 33114168 |
| INTERNATIONAL JOURNAL OF BIOLOGICAL MACROMOLECULES | Physicochemical characterization and immunomodulatory activity of sulfated Chinese yam polysaccharide Pubmed: 33010421 |
| Pharmaceutics | Locally Applied Slow-Release of Minocycline Microspheres in the Treatment of Peri-Implant Mucositis: An Experimental In Vivo Study Pubmed: 32708741 |
| BIOLOGICAL TRACE ELEMENT RESEARCH | Association Between Serum Selenium Level and Subclinical Mastitis in Dairy Cattle Pubmed: 32583225 |
| Molecular Medicine Reports | Neuropeptide Y upregulates Runx2 and osterix and enhances osteogenesis in mouse MC3T3‑E1 cells via an autocrine mechanism Pubmed: 33000198 |
| South African Journal of Botany | Evaluation of the effect of herbal extracts and their bioactive compounds against motion sickness by regulating neurotransmitter levels in vitro and in vivo |
| Journal of Functional Foods | Comparison of immunomodulatory effects of three polysaccharide fractions from Lentinula edodes water extracts |
| Italian Journal of Animal Science | Effects of chitooligosaccharide supplementation on laying performance, egg quality, blood biochemistry, antioxidant capacity and immunity of laying hens during the … |
| Regenerative Biomaterials | A comparative study of autogenous, allograft and artificial bone substitutes on bone regeneration and immunotoxicity in rat femur defect model |
| ACS APPLIED BIO MATERIALS | Curcumin loaded nanostructure hybrid lipid capsules for co-eradication of breast cancer and cancer stem cells with enhanced anticancer efficacy |
| 博士论文 | Women Scientist Scientist Mentor |
| sensors and actuators b-chemical | A light-induced self-powered competitive immunosensor for the detection of platelet derived growth factor-BB via an elaborately assembled bioconjugate |
| THERANOSTICS | Visualized podocyte-targeting and focused ultrasound responsive glucocorticoid nano-delivery system against immune-associated nephropathy without?¡ 33456566 |
| Life Sci | Celecoxib ameliorates liver cirrhosis via reducing inflammation and oxidative stress along spleen-liver axis in rats 33577848 |
| Animals (Basel) | Handling Associated with Drenching Does Not Impact Survival and General Health of Low Birth Weight Piglets. Animals 2021, 11, 404 33562568 |
| Environ Pollut | Trace endotoxin in reclaimed water is only one of the risk sources in subchronic inhalation exposure 34090073 |
| Veterinary Microbiology | Optimized GAPDH-truncated immunogen of Streptococcus equi elicits an enhanced immune response and provides effective protection in a mouse model 33647714 |
| Experimental and Therapeutic Medicine | Insulin-like growth factor-1 improves postoperative cognitive dysfunction following splenectomy in aged rats 33574912 |
| British Journal of Pharmacology | The suppression of Brd4 inhibits peripheral plasma cell differentiation and exhibits therapeutic potential for systemic lupus erythematosus |
| Journal of Chinese Pharmaceutical Sciences | A simple and sensitive electrochemical impedimetric immunosensor for the detection of apolipoprotein E4 based on CeZnO nanoparticle |
| Neonatal Buza??larda ?ki Farkl? ?mmunomod¨¹lat?r¨¹n Buza?? ?shalleri ¨¹zerine Etkileri | |
| Microbiology Spectrum | Dietary Supplementation of Inulin Ameliorates Subclinical Mastitis via Regulation of Rumen Microbial Community and Metabolites in Dairy Cows 34494854 |
| Pediatrics International | Prenatal diagnosis of maternal serum from mothers carrying β‐thalassemic fetus 34559910 |
| Toxicology | Protection from Benzene-induced Immune Dysfunction in Mice Pubmed:35090963 |
| Food Funct | Three Urban of China: A Cohort Study of Maternal-Infant Factors and HM Protein Components Pubmed:35438093 |
| Cell Death & Disease | Proteomic analysis reveals USP7 as a novel regulator of palmitic acid-induced hepatocellular carcinoma cell death Pubmed:35732625 |
| Nature Communications | Integrative epigenomic and transcriptomic analysis reveals the requirement of JUNB for hematopoietic fate induction Pubmed:35668082 |
| Food and Agricultural Immunology | The effect of the multi-strain probiotic preparation EM Bokashi® on selected parameters of the cellular immune response in pigs |
| 陆军军医大学学报 | 信筒子醌对系统性红斑狼疮小鼠免疫调节和治疗作用 |